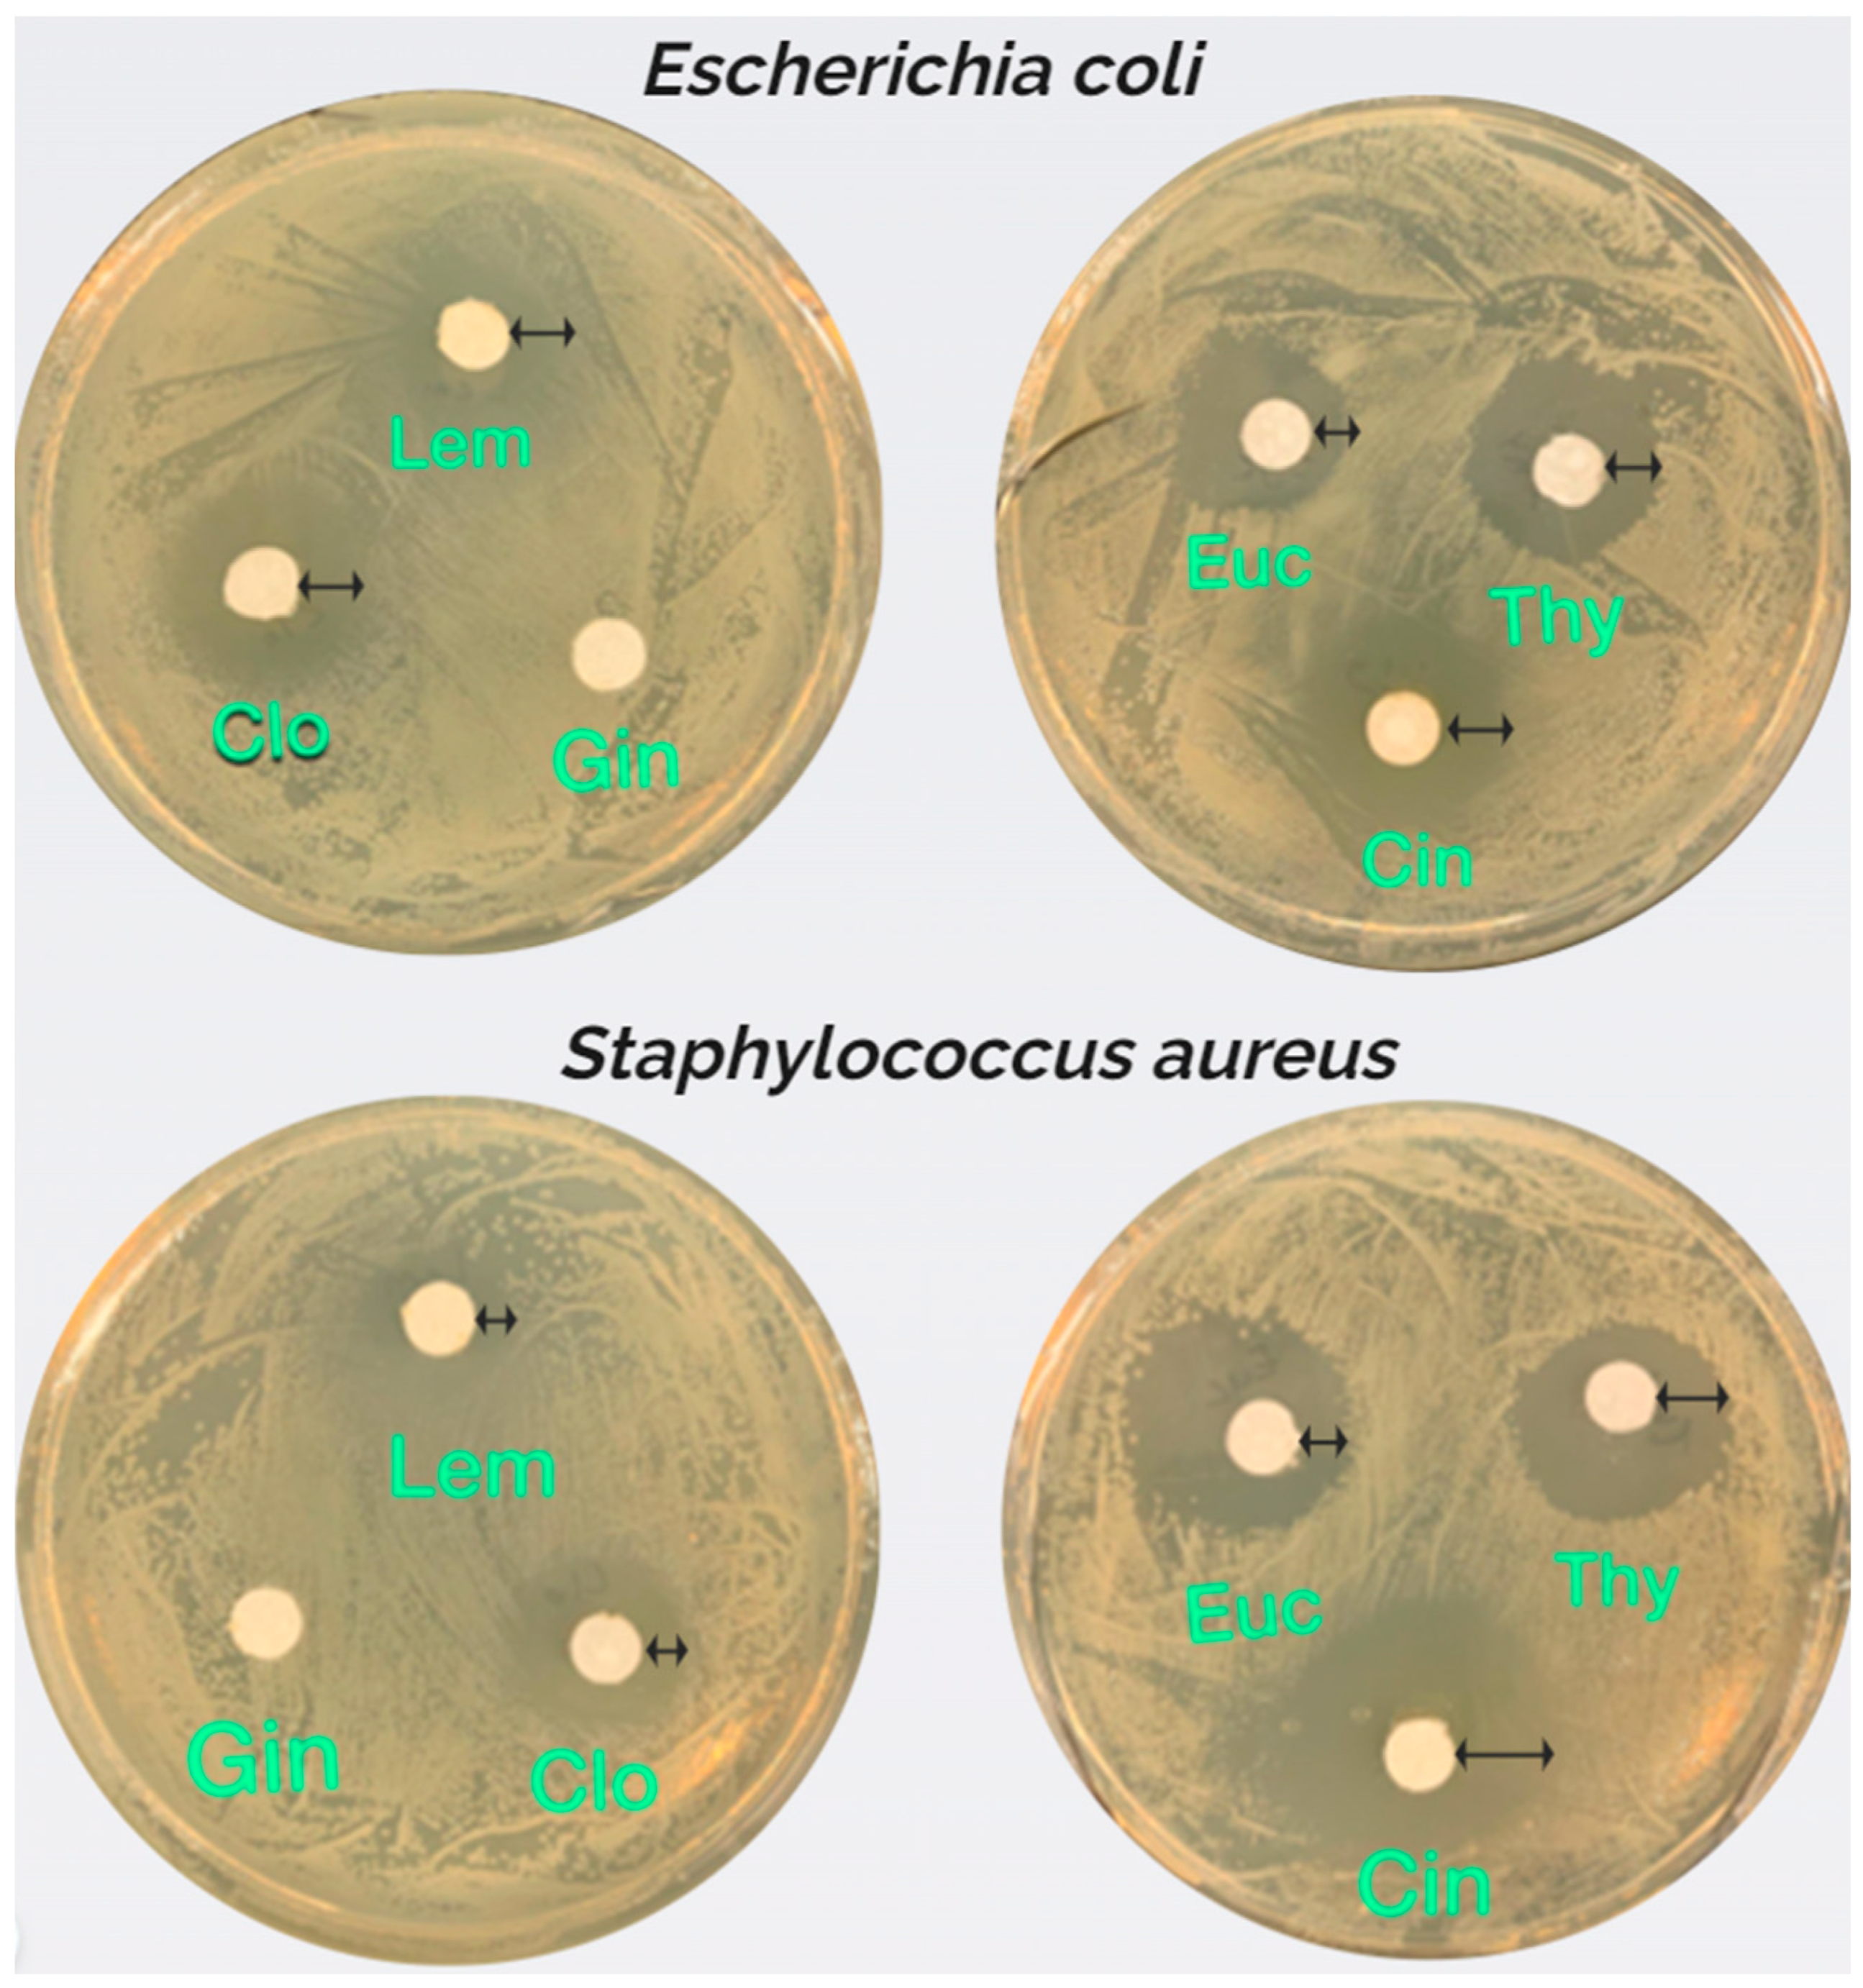

Development of Antimicrobial Blends of Bacteria Nanocellulose Derived from Plastic Waste and Polyhydroxybutyrate Enhanced with Essential Oils
Abstract
1. Introduction
2. Materials and Methods
2.1. Microorganisms and Culture Condition
2.2. Antimicrobial Blends Preparation
2.2.1. Essential Oils Selection
2.2.2. BNC-Based Blends Preparation
2.3. Material Characterization
2.3.1. Blends Morphology
2.3.2. Scanning Electron Microscopy (SEM)
2.3.3. Tensile Testing
2.3.4. Thermogravimetric Analysis (TGA)
2.3.5. Fourier Transform Infrared Spectroscopy Analysis (FT-IR)
2.4. Antimicrobial Assessment
2.4.1. Minimum Inhibitory Concentration (MIC)
2.4.2. Determination of Biofilm Inhibition Activity
2.4.3. Caenorhabditis Elegans Survival Assay
3. Results and Discussion
3.1. Essential Oils Selection
Essential Oils Minimum Inhibitory Concentration (MIC)
3.2. Blends Morphology
3.3. Scanning Electron Microscopy (SEM)
3.4. Tensile Properties
3.5. Thermogravimetric Analysis (TGA)
3.6. Fourier Transform Infrared Spectroscopy Analysis (FT-IR)
3.7. Antimicrobial Activity
3.8. Determination of Anti-Biofilm Activity
3.9. Caenorhabditis Elegans Survival Curves
4. Conclusions
Author Contributions
Funding
Institutional Review Board Statement
Data Availability Statement
Conflicts of Interest
References
- Pan, D.; Su, F.; Liu, C.; Guo, Z. Research Progress for Plastic Waste Management and Manufacture of Value-Added Products. Adv. Compos. Hybrid Mater. 2020, 3, 443–461. [Google Scholar] [CrossRef]
- Khan, S.; Ul-Islam, M.; Ullah, M.W.; Zhu, Y.; Narayanan, K.B.; Han, S.S.; Park, J.K. Fabrication Strategies and Biomedical Applications of Three-Dimensional Bacterial Cellulose-Based Scaffolds: A Review. Int. J. Biol. Macromol. 2022, 209, 9–30. [Google Scholar] [CrossRef] [PubMed]
- RameshKumar, S.; Shaiju, P.; O’Connor, K.E. Bio-Based and Biodegradable Polymers—State-of-the-Art, Challenges and Emerging Trends. Curr. Opin. Green Sustain. Chem. 2020, 21, 75–81. [Google Scholar] [CrossRef]
- Torres, F.G.; Commeaux, S.; Troncoso, O.P. Biocompatibility of Bacterial Cellulose Based Biomaterials. J. Funct. Biomater. 2012, 3, 864–878. [Google Scholar] [CrossRef]
- Attallah, O.A.; Mojicevic, M.; Garcia, E.L.; Azeem, M.; Chen, Y.; Asmawi, S.; Brenan Fournet, M. Macro and Micro Routes to High Performance Bioplastics: Bioplastic Biodegradability and Mechanical and Barrier Properties. Polymers 2021, 13, 2155. [Google Scholar] [CrossRef] [PubMed]
- Fernandes, I.d.A.A.; Pedro, A.A.; Ribeiro, V.R.; Bortolini, D.G.; Ozaki, M.S.C.; Maciel, G.M.; Haminiuk, C.W.I. Bacterial Cellulose: From Production Optimization to New Applications. Int. J. Biol. Macromol. 2020, 164, 2598–2611. [Google Scholar] [CrossRef]
- Ul-Islam, M.; Ullah, M.W.; Khan, S.; Park, J.K. Production of Bacterial Cellulose from Alternative Cheap and Waste Resources: A Step for Cost Reduction with Positive Environmental Aspects. Korean J. Chem. Eng. 2020, 37, 925–937. [Google Scholar] [CrossRef]
- Ogunsona, E.O.; Mekonnen, T.H. Multilayer Assemblies of Cellulose Nanocrystal—Polyvinyl Alcohol Films Featuring Excellent Physical Integrity and Multi-Functional Properties. J. Colloid Interface Sci. 2020, 580, 56–67. [Google Scholar] [CrossRef]
- Schmitz, F.; Silva de Albuquerque, M.B.; Alberton, M.D.; Riegel-Vidotti, I.C.; Zimmermann, L.M. Zein Films with ZnO and ZnO:Mg Quantum Dots as Functional Nanofillers: New Nanocomposites for Food Package with UV-Blocker and Antimicrobial Properties. Polym. Test. 2020, 91, 106709. [Google Scholar] [CrossRef]
- Singhania, R.R.; Patel, A.K.; Tsai, M.-L.; Chen, C.-W.; Di Dong, C. Genetic Modification for Enhancing Bacterial Cellulose Production and Its Applications. Bioengineered 2021, 12, 6793–6807. [Google Scholar] [CrossRef]
- Bharti, S.N.; Swetha, G. Need for Bioplastics and Role of Biopolymer PHB: A Short Review. J. Pet Environ. Biotechnol. 2016, 7, 2. [Google Scholar] [CrossRef]
- Koller, M. A Review on Established and Emerging Fermentation Schemes for Microbial Production of Polyhydroxyalkanoate (PHA) Biopolyesters. Fermentation 2018, 4, 30. [Google Scholar] [CrossRef]
- Sindhu, R.; Ammu, B.; Binod, P.; Deepthi, S.K.; Ramachandran, K.B.; Soccol, C.R.; Pandey, A. Production and Characterization of Poly-3-Hydroxybutyrate from Crude Glycerol by Bacillus Sphaericus NII 0838 and Improving Its Thermal Properties by Blending with Other Polymers. Braz. Arch. Biol. Technol. 2011, 54, 783–794. [Google Scholar] [CrossRef]
- McAdam, B.; Brennan Fournet, M.; McDonald, P.; Mojicevic, M. Production of Polyhydroxybutyrate (PHB) and Factors Impacting Its Chemical and Mechanical Characteristics. Polymers 2020, 12, 2908. [Google Scholar] [CrossRef]
- Aramvash, A.; Gholami-Banadkuki, N.; Moazzeni-Zavareh, F.; Hajizadeh-Turchi, S. An Environmentally Friendly and Efficient Method for Extraction of PHB Biopolymer with Non-Halogenated Solvents. J. Microbiol. Biotechnol. 2015, 25, 1936–1943. [Google Scholar] [CrossRef] [PubMed]
- Aramvash, A.; Moazzeni Zavareh, F.; Gholami Banadkuki, N. Comparison of Different Solvents for Extraction of Polyhydroxybutyrate from Cupriavidus Necator. Eng. Life Sci. 2018, 18, 20–28. [Google Scholar] [CrossRef]
- Saleha, S.; Helwati, H. Effect of Natural Ingredients Addition as Antimicrobial Agents in Dioscoreahispida Dennst Starch-Based Biofilm. In IOP Conference Series: Earth and Environmental Science; IOP Publishing: Bristol, UK, 2019; Volume 364, p. 012006. [Google Scholar] [CrossRef]
- Contessa, C.R.; da Rosa, G.S.; Moraes, C.C. New Active Packaging Based on Biopolymeric Mixture Added with Bacteriocin as Active Compound. Int. J. Mol. Sci. 2021, 22, 10628. [Google Scholar] [CrossRef] [PubMed]
- Burt, S. Essential Oils: Their Antibacterial Properties and Potential Applications in Foods—A Review. Int. J. Food Microbiol. 2004, 94, 223–253. [Google Scholar] [CrossRef]
- Yammine, J.; Chihib, N.-E.; Gharsallaoui, A.; Dumas, E.; Ismail, A.; Karam, L. Essential Oils and Their Active Components Applied as: Free, Encapsulated and in Hurdle Technology to Fight Microbial Contaminations. A Review. Heliyon 2022, 8, e12472. [Google Scholar] [CrossRef] [PubMed]
- Pereira, E.H.D.S.; Attallah, O.A.; Tas, C.E.; Chee, B.S.; Freitas, F.; Garcia, E.L.; Auliffe, M.A.P.M.; Mojicevic, M.; Batista, M.N.; Reis, M.A.M.; et al. Boosting Bacterial Nanocellulose Production from Chemically Recycled Post-Consumer Polyethylene Terephthalate. Sustain. Mater. Technol. 2024, 39, e00784. [Google Scholar] [CrossRef]
- Tomić, A.; Šovljanski, O.; Erceg, T. Insight on Incorporation of Essential Oils as Antimicrobial Substances in Biopolymer-Based Active Packaging. Antibiotics 2023, 12, 1473. [Google Scholar] [CrossRef]
- Gheorghita Puscaselu, R.; Lobiuc, A.; Sirbu, I.O.; Covasa, M. The Use of Biopolymers as a Natural Matrix for Incorporation of Essential Oils of Medicinal Plants. Gels 2022, 8, 756. [Google Scholar] [CrossRef] [PubMed]
- Ataei, S.; Azari, P.; Hassan, A.; Pingguan-Murphy, B.; Yahya, R.; Muhamad, F. Essential Oils-Loaded Electrospun Biopolymers: A Future Perspective for Active Food Packaging. Adv. Polym. Technol. 2020, 2020, 9040535. [Google Scholar] [CrossRef]
- Devi, L.S.; Das, B.; Dutta, D.; Kumar, S. Essential Oils as Functional Agents in Biopolymer-Based Sustainable Food Packaging System: A Review. Sustain. Chem. Pharm. 2024, 39, 101563. [Google Scholar] [CrossRef]
- Hossen, M.A.; Shimul, I.M.; Sameen, D.E.; Rasheed, Z.; Dai, J.; Li, S.; Qin, W.; Tang, W.; Chen, M.; Liu, Y. Essential Oil–Loaded Biopolymeric Particles on Food Industry and Packaging: A Review. Int. J. Biol. Macromol. 2024, 265, 130765. [Google Scholar] [CrossRef] [PubMed]
- Hasan, J.; Crawford, R.J.; Ivanova, E.P. Antibacterial Surfaces: The Quest for a New Generation of Biomaterials. Trends Biotechnol. 2013, 31, 295–304. [Google Scholar] [CrossRef] [PubMed]
- Anbukarasu, P.; Sauvageau, D.; Elias, A. Tuning the Properties of Polyhydroxybutyrate Films Using Acetic Acid via Solvent Casting. Sci. Rep. 2015, 5, 17884. [Google Scholar] [CrossRef]
- Gostick, J.; Khan, Z.; Tranter, T.; Kok, M.; Agnaou, M.; Sadeghi, M.; Jervis, R. PoreSpy: A Python Toolkit for Quantitative Analysis of Porous Media Images. JOSS 2019, 4, 1296. [Google Scholar] [CrossRef]
- Nostro, A.; Guerrini, A.; Marino, A.; Tacchini, M.; Di Giulio, M.; Grandini, A.; Akin, M.; Cellini, L.; Bisignano, G.; Saraçoğlu, H.T. In Vitro Activity of Plant Extracts against Biofilm-Producing Food-Related Bacteria. Int. J. Food Microbiol. 2016, 238, 33–39. [Google Scholar] [CrossRef] [PubMed]
- Stiernagle, T. Maintenance of C. Elegans. In The C. elegans Research Community, WormBook; WormBook, Ed.; Caenorhabditis Genetics Center, University of Minnesota: Minneapolis, MN, USA, 2006. [Google Scholar] [CrossRef]
- Brackman, G.; Cos, P.; Maes, L.; Nelis, H.J.; Coenye, T. Quorum Sensing Inhibitors Increase the Susceptibility of Bacterial Biofilms to Antibiotics In Vitro and In Vivo. Antimicrob. Agents Chemother. 2011, 55, 2655–2661. [Google Scholar] [CrossRef]
- Davidson-Pilon, C. Lifelines: Survival Analysis in Python. JOSS 2019, 4, 1317. [Google Scholar] [CrossRef]
- Jeong, Y.-J.; Kim, H.-E.; Han, S.-J.; Choi, J.-S. Antibacterial and Antibiofilm Activities of Cinnamon Essential Oil Nanoemulsion against Multi-Species Oral Biofilms. Sci. Rep. 2021, 11, 5911. [Google Scholar] [CrossRef] [PubMed]
- Fernandes, S.C.M.; Oliveira, L.; Freire, C.S.R.; Silvestre, A.J.D.; Neto, C.P.; Gandini, A.; Desbriéres, J. Novel Transparent Nanocomposite Films Based on Chitosan and Bacterial Cellulose. Green Chem. 2009, 11, 2023–2029. [Google Scholar] [CrossRef]
- Barud, H.S.; Souza, J.L.; Santos, D.B.; Crespi, M.S.; Ribeiro, C.A.; Messaddeq, Y.; Ribeiro, S.J.L. Bacterial Cellulose/Poly(3-Hydroxybutyrate) Composite Membranes. Carbohydr. Polym. 2011, 83, 1279–1284. [Google Scholar] [CrossRef]
- Mautner, A.; Bismarck, A. Bacterial Nanocellulose Papers with High Porosity for Optimized Permeance and Rejection of Nm-Sized Pollutants. Carbohydr. Polym. 2021, 251, 117130. [Google Scholar] [CrossRef] [PubMed]
- Gostick, J.T. Versatile and Efficient Pore Network Extraction Method Using Marker-Based Watershed Segmentation. Phys. Rev. E 2017, 96, 023307. [Google Scholar] [CrossRef] [PubMed]
- Barud, H.d.S.; UNESP. Materiais Multifuncionais Baseados Em Celulose Bacteriana. 2010. Available online: http://hdl.handle.net/11449/105766 (accessed on 5 December 2024).
- Sheykhnazari, S.; Tabarsa, T.; Ashori, A.; Shakeri, A.; Golalipour, M. Bacterial Synthesized Cellulose Nanofibers; Effects of Growth Times and Culture Mediums on the Structural Characteristics. Carbohydr. Polym. 2011, 86, 1187–1191. [Google Scholar] [CrossRef]
- Babos, G.; Rydz, J.; Kawalec, M.; Klim, M.; Fodor-Kardos, A.; Trif, L.; Feczkó, T. Poly(3-Hydroxybutyrate)-Based Nanoparticles for Sorafenib and Doxorubicin Anticancer Drug Delivery. Int. J. Mol. Sci. 2020, 21, 7312. [Google Scholar] [CrossRef] [PubMed]
- Herrera, D.A.G.; Mojicevic, M.; Venkatesh, C.; Da Silva Pereira, E.H.; Brennan Fournet, M. Unveiling the Potential of Bacterial Isolates from Plastic-Polluted Environments: Enhancement of Polyhydroxybutyrate Biodegradation. Biotechnol. Environ. 2024, in press. [Google Scholar] [CrossRef]
- Râpă, M.; Zaharia, C.; Stănescu, P.O.; Cășărică, A.; Matei, E.; Predescu, A.M.; Pantilimon, M.C.; Vidu, R.; Predescu, C.; Cioflan, H. In Vitro Degradation of PHB/Bacterial Cellulose Biocomposite Scaffolds. Int. J. Polym. Sci. 2021, 2021, 3820364. [Google Scholar] [CrossRef]
- Islam, N.; Proma, S.J.; Rahman, A. Preparation and Biodegradation of Nanocellulose Reinforced Polyvinyl Alcohol Blend Films in Bioenvironmental Media. Chem. Sci. Int. J. 2017, 19, 1–8. [Google Scholar] [CrossRef]
- Aguilar-Sánchez, A.; Li, J.; Jalvo, B.; Pesquet, E.; Mathew, A.P. Understanding the Effect of Different Nanocelluloses on the Proliferation and Biomechanical Properties of E. Coli. Cell Rep. Phys. Sci. 2024, 5, 102226. [Google Scholar] [CrossRef]
- Walling, B.; Bharali, P.; Giridharan, B.; Gogoi, B.; Sorhie, V.; Mani, S.K. Bacterial Nanocellulose: A Novel Nanostructured Bio-Adsorbent for Green Remediation Technology. Acta Ecol. Sin. 2023, 43, 946–967. [Google Scholar] [CrossRef]
- Shu, C.; Ge, L.; Li, Z.; Chen, B.; Liao, S.; Lu, L.; Wu, Q.; Jiang, X.; An, Y.; Wang, Z.; et al. Antibacterial Activity of Cinnamon Essential Oil and Its Main Component of Cinnamaldehyde and the Underlying Mechanism. Front. Pharmacol. 2024, 15, 1378434. [Google Scholar] [CrossRef] [PubMed]

| Composition | Abbreviations |
|---|---|
| 2% (w/w) PHB, dried BNC powder, 1% cinnamon leaf oil (v/v), solubilized in glacial acetic acid. | BPHB2 |
| 5% (w/w) PHB, dried BNC powder, 1% cinnamon leaf oil (v/v), solubilized in glacial acetic acid. | BPHB5 |
| 10% (w/w) PHB, dried BNC powder, 1% cinnamon leaf oil (v/v), solubilized in glacial acetic acid. | BPHB10 |
| 38.48% (w/w) BNC, 15% (w/w) polyethylene glycol (PEG), 15% (w/w) glycerol, 15% (w/w) Tween 80, 15% (w/w) PHA-rich biomass, 1% cinnamon leaf oil (v/v), solubilized in water | BPST |
| 40% (w/w) BNC, 20% (w/w) glycerol, 20% (w/w) polyvinyl alcohol (PVA), 20% (w/w) PHA-rich biomass, 1% cinnamon leaf oil (v/v), solubilized in ethanol | BPSE |
| 40% (w/w) BNC, 20% (w/w) glycerol, 20% (w/w) PVA, 20% (w/w) PHA-rich biomass, 1% cinnamon leaf oil (v/v), solubilized in water | BPSW |
| Sample | Young’s Modulus at 0.2% (E) [MPa] | Ultimate Tensile Strength (UTS) [MPa] | Strain at UTS (εUTS) [%] | Stress at Break (σB) [MPa] | Strain at Break (εB) [%] |
|---|---|---|---|---|---|
| BNC | 1703.5 ± 221.5 | 27.9 ± 9.5 | 8.8 ± 3.8 | 27.8 ± 9.6 | 9.0 ± 3.7 |
| BPHB2 | 912.3 ± 540.7 | 14.2 ± 7.1 | 4.8 ± 0.2 | 13.9 ± 7.5 | 5.0 ± 0.2 |
| BPHB5 | 1173.7 ± 11.4 | 15.5 ± 3.6 | 3.6 ± 0.9 | 15.5 ± 3.6 | 3.7 ± 0.8 |
| BPHB10 | 657.4 ± 126.5 | 6.9 ± 1.7 | 3.3 ± 0.6 | 6.7 ± 1.5 | 3.5 ± 0.5 |
Disclaimer/Publisher’s Note: The statements, opinions and data contained in all publications are solely those of the individual author(s) and contributor(s) and not of MDPI and/or the editor(s). MDPI and/or the editor(s) disclaim responsibility for any injury to people or property resulting from any ideas, methods, instructions or products referred to in the content. |
© 2024 by the authors. Licensee MDPI, Basel, Switzerland. This article is an open access article distributed under the terms and conditions of the Creative Commons Attribution (CC BY) license (https://creativecommons.org/licenses/by/4.0/).
Share and Cite
Da Silva Pereira, E.H.; Nicevic, M.; Garcia, E.L.; Moritz, V.F.; Ozcelik, Z.E.; Tas, B.A.; Fournet, M.B. Development of Antimicrobial Blends of Bacteria Nanocellulose Derived from Plastic Waste and Polyhydroxybutyrate Enhanced with Essential Oils. Polymers 2024, 16, 3490. https://doi.org/10.3390/polym16243490
Da Silva Pereira EH, Nicevic M, Garcia EL, Moritz VF, Ozcelik ZE, Tas BA, Fournet MB. Development of Antimicrobial Blends of Bacteria Nanocellulose Derived from Plastic Waste and Polyhydroxybutyrate Enhanced with Essential Oils. Polymers. 2024; 16(24):3490. https://doi.org/10.3390/polym16243490
Chicago/Turabian StyleDa Silva Pereira, Everton Henrique, Marija Nicevic, Eduardo Lanzagorta Garcia, Vicente Fróes Moritz, Zeliha Ece Ozcelik, Buket Alkan Tas, and Margaret Brennan Fournet. 2024. "Development of Antimicrobial Blends of Bacteria Nanocellulose Derived from Plastic Waste and Polyhydroxybutyrate Enhanced with Essential Oils" Polymers 16, no. 24: 3490. https://doi.org/10.3390/polym16243490
APA StyleDa Silva Pereira, E. H., Nicevic, M., Garcia, E. L., Moritz, V. F., Ozcelik, Z. E., Tas, B. A., & Fournet, M. B. (2024). Development of Antimicrobial Blends of Bacteria Nanocellulose Derived from Plastic Waste and Polyhydroxybutyrate Enhanced with Essential Oils. Polymers, 16(24), 3490. https://doi.org/10.3390/polym16243490

